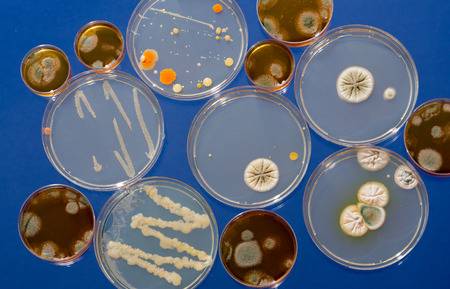

Contents
Conheça melhor o curso de Microbiologia
Microbiologia é o ramo da biologia que estuda os microrganismos. Os microrganismos são seres vivos minúsculos que só podem ser visualizados pelo homem através do microscópio.
Estude com a iEstudar Cursos Online o curso de Microbiologia.
Grupos de Microrganismo
Os grupos de microrganismo são os fungos, bactérias, vírus e protozoários.
Fungos: pertencem ao Reino Fungi e possuem diversos tipos de habitat. Eles são utilizados para diversos fins, como na produção de medicamentos, na culinária e na fabricação de produtos. Entre as doenças causadas pelo fungo podemos citar: micose, candidíase, sapinho, dentre outros.
Bactérias:pertencem ao Reino Monera e possuem diversas funções. Elas atuam na fabricação de antibióticos, na produção de proteínas humanas, na fabricação de vitaminas, além de ajudar na decomposição de matérias orgânica morta.
Dentre as doenças causadas por bactérias podemos citar: difteria, lepra, tuberculose, cólera, dentre outros.
Vírus: são considerados intracelulares, pois não possuem células. São responsáveis por provocar doenças graves como: caxumba, varíola, HIV, febre amarela, dentre outras.
Protozoários: pertencem ao Reino Protista e podem causar também algumas doenças como: malária, doenças de chagas, giardíase, dentre outros.
Qual a importância da Microbiologia
O estudo da microbiologia é muito importante, pois ela permite conhecer os microrganismos mais a fundo e o seu papel em nossas vidas.
Os microrganismos muitas vezes são lembrados apenas como causadores de doenças, mas a maioria é muito benéfica.
A Microbiologia é importante para o ambiente, na fabricação de medicamentos, na agricultura, na fabricação de alimentos e para o estudo de diversas doenças. Podemos concluir, que o conhecimento em microbiologia é de extrema importância.
Certificado do curso online grátis de Microbiologia
Um certificado de um curso livre pode ser válido para diversas finalidades, como por exemplo:
- Educação continuada
- Atividades complementares em faculdades
- Titularidade para professores
- Complementação de conhecimento
- Ascensão de carreira
- Contagem de carga horária
- Comprovação de Prova de Título
- Enriquecimento de currículo
- Concursos públicos
- Avaliações para promoções internas nas empresas
- Dentre outros…
TOP 10 cursos online do iEstudar
Psicologia Aplicada à Nutrição
-> CURSO ONLINE GRÁTIS de Psicologia Aplicada à Nutrição com opção de certificado válido!
Nutrição e Dietética
-> CURSO ONLINE GRÁTIS de Nutrição e Dietética com opção de certificado válido!
Nutrição
-> CURSO ONLINE GRÁTIS de Nutrição com opção de certificado válido!
Nutrição Animal
-> CURSO ONLINE GRÁTIS de Nutrição Animal com opção de certificado válido!
Nutrição Escolar
-> CURSO ONLINE GRÁTIS de Nutrição Escolar com opção de certificado válido!
Meio Ambiente e Recursos Sustentáveis
-> CURSO ONLINE GRÁTIS de Meio Ambiente e Recursos Sustentáveis com opção de certificado válido!
Nutrição Esportiva para Iniciantes
-> CURSO ONLINE GRÁTIS de Nutrição Esportiva para Iniciantes com opção de certificado válido!
Nutrição Fitness
-> CURSO ONLINE GRÁTIS de Nutrição Fitness com opção de certificado válido!
Boas Práticas de Alimentação
-> CURSO ONLINE GRÁTIS de Boas Práticas de Alimentação com opção de certificado válido!
Alimentação Saudável
-> CURSO ONLINE GRÁTIS de Alimentação Saudável com opção de certificado válido!
Não perca mais tempo e venha estudar no iEstudar Cursos Online!